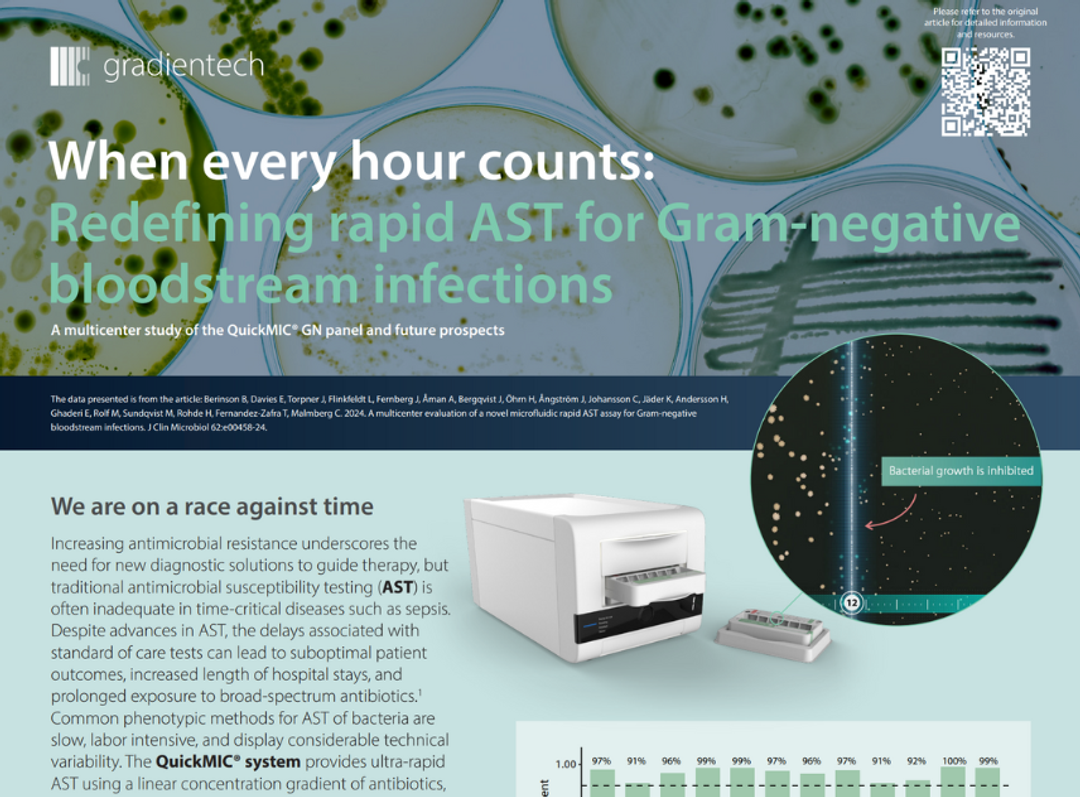

CLINICAL24 Sepsis Spotlight
Find the latest research news and technological innovations in sepsis diagnostics
Sepsis is a major global health concern, causing millions of deaths annually, and frequent adverse events in healthcare settings due to drug-resistant pathogens. During CLINICAL24, it became clear that sepsis is high on the agenda for laboratory and healthcare professionals. In this brand new Sepsis Spotlight, hear from experts and learn about the latest in sepsis diagnostics. You can browse our latest interviews and videos, download case studies and infographics, and watch sessions from the 2024 World Sepsis Congress Spotlight.

A few days ago, three world-renowned sepsis experts sat down together for this unique roundtable discussion exploring the current situation in global sepsis diagnostics and management. Learn about the global sepsis agenda and understand current challenges facing clinical labs and healthcare systems. Don't miss this unique opportunity to listen to Dr. Ron Daniels, CEO of the UK Sepsis Trust, Mariam Jashi, CEO of the Global Sepsis Alliance, and Ephraim Tsalik, VP & Chief Scientific Officer, Danaher Diagnostics as they discuss sepsis diagnostics and the global sepsis agenda together.
Watch todayPost-pandemic, hospital-onset infections from resistant pathogens have surged, with significant increases in carbapenem-resistant, ESßL-producing, and multidrug-resistant infections. Download this resource to discover how Beckman Coulter’s MicroScan systems provide accurate, timely resistance detection, supporting better antimicrobial therapy decisions to combat this costly and deadly condition.
Download infographicSepsis is a life-threatening condition caused by a dysregulated immune response to infection, affecting over 48 million people annually. Early diagnosis is key to effective treatment. Download this infographic to discover how Beckman Coulter solutions can support laboratories in suspecting, diagnosing, and confirming sepsis to improve outcomes. Plus, explore the innovations that help clinicians navigate diagnostic uncertainty and enhance antimicrobial stewardship.
Download infographic2024 World Sepsis Congress Spotlight highlighted talks
View the 2024 WSC Spotlight program here
The QuickMIC® system delivers ultra-rapid antimicrobial susceptibility testing with precise MIC values, offering significant improvements in speed, accuracy, and reproducibility over traditional methods, crucial for managing time-critical diseases like sepsis.
Download case study
MDx-Chex® controls from Streck provide a comprehensive, all-in-one solution for quality control of molecular diagnostics instruments. They ensure accurate performance in sepsis tests by monitoring the entire assay process, from cell lysis to nucleic acid analysis.
Watch video